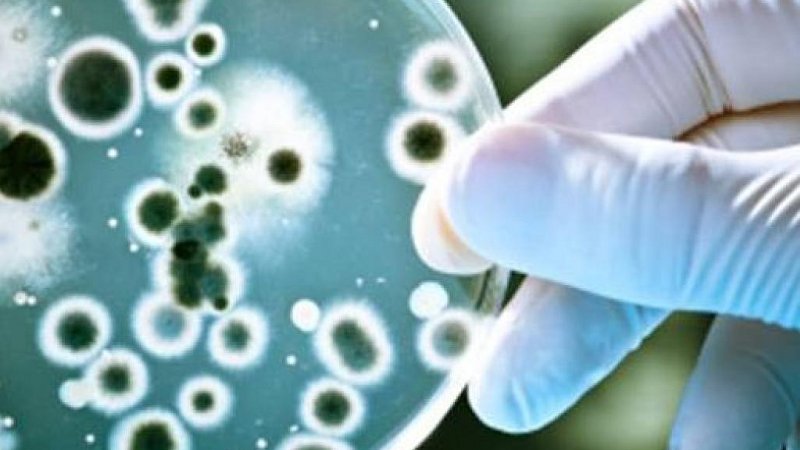
Resistente VRE-bacterie aangetroffen op verpleegafdeling Dijklander Ziekenhuis in Hoorn

Laatste nieuws
120 berichten gevonden
Dijklander Ziekenhuis organiseert proeverij voor smaakverandering bij kanker
02-05-2022 | 16:39:19
HOORNGIDS HOORN | Het Dijklander Ziekenhuis organiseert op zaterdag 14 mei en zaterdag 8 oktober een proeverij voor patiënten die chemotherapie krijgen. Zij merken namelijk vaak dat hun eten door de behandeling niet meer smaakt zoals voorheen. Ze ervaren smaakverlies of hun smaak vermindert of is…
Nieuwe techniek voor efficiëntere borstsparende borstkankeroperaties in Dijklander Ziekenhuis
16-02-2022 | 09:57:00
HOORNGIDS REGIO | Een klein lichtpuntje voor borstkankerpatiënten: de nieuwe techniek Pintuition, waar het Dijklander Ziekenhuis sinds kort mee werkt, maakt het mogelijk een tumor eenvoudiger op te sporen en te opereren. Na een proefperiode en evaluatie, is deze nieuwe techniek sinds 1 januari de…
Resistente VRE-bacterie aangetroffen op verpleegafdeling Dijklander Ziekenhuis in Hoorn
02-02-2022 | 07:16:00
HOORNGIDS HOORN | Op de verpleegafdeling van het Dijklander Ziekenhuis in Hoorn is de VRE-bacterie aangetroffen bij een van de patiënten. De afdeling infectiepreventie is een contactonderzoek gestart en er zijn volgens de richtlijnen direct maatregelen genomen om verdere verspreiding te…
Nieuwe app Dijklander Ziekenhuis begeleidt orthopediepatiënt tijdens behandeltraject
01-02-2022 | 15:48:13
HOORNGIDS REGIO | De vakgroep Orthopedie van het Dijklander Ziekenhuis zet vanaf vandaag de ‘Patient Journey App’ in bij de voorlichting voor patiënten die een heup- of knieoperatie ondergaan. Deze app biedt informatie op maat en begeleidt de patiënt gedurende het gehele traject rondom de ingreep.…
Lot Winkel per 1 mei nieuw lid raad van bestuur Dijklander Ziekenhuis
01-02-2022 | 09:57:00
HOORNGIDS HOORN | De raad van commissarissen van het Dijklander Ziekenhuis heeft Lot Winkel benoemd als lid van de raad van bestuur/ CFO. Zij start 1 mei a.s. en volgt interim bestuurder Ankie van Rossum op. Winkel heeft ruime ervaring als divisiemanager in de ziekenhuiszorg en als CFO in het…
Laatste nieuws |
Tagcloud
- burgemeester jan nieuwenburg
- coronacrisis
- coronapatinten
- coronavirus
- expositie
- hoorn
- maatregelen
- proeverij
- voorlichtingsavond
- workshop
Gerelateerde reacties
Kees
11-09-2024 | 00:07:25
En weer worden de zorgkosten verhoogd wat niets met zorg te maken heeft
Het enigste doel is om de clienten uiteindelijk te leren om digitaal een consult te doen wat zogenaamd besparend is voor het zi…
Bert Putters
05-03-2024 | 13:18:18
Onbegrijpelijk. Orthopeed stuurt je naar huis; "Moet met rust genezen". En in een kliniek wordt nee halve prothese geplaats. met de woorden: "Ze hadden je nooit naar huis mogen sturen". Wachtlijsten v…
Kees
07-10-2023 | 00:21:01
Mooi loze woorden van deze man hier zijn al dat soort mensen wel sterk in maar als hij nou begint met het contact centrum af te schaffen doet hij toch iets goed.
Zoeken in nieuws
U heeft gezocht op: dijklander ziekenhuis
Onze Facebook pagina |
Contactgegevens |
Laat hier uw tip achter
Adres
| Locatie | Zoeken
Sitemap
|
Copyright 2026 - HoornRadio / HoornGids